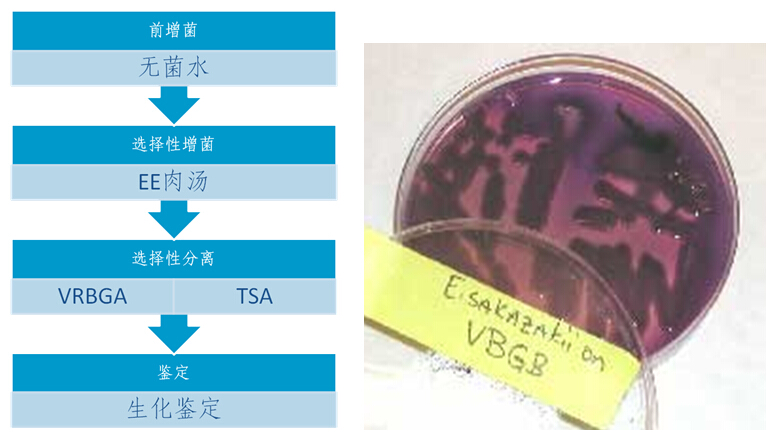

海博微信公众号
海博微信公众号
 海博天猫旗舰店
海博天猫旗舰店


 海博微信公众号
海博微信公众号
 海博天猫旗舰店
海博天猫旗舰店

优点:所使用的各种培养基常见、价格便宜,更易普及。
缺点:选择性差
1、EE broth:竞争性抑制作用
2、VRBGA:(1)其它细菌也能生长,产生粉紫色菌落,胆汁酸沉淀形成紫色晕圈;(2)ES无特征性菌落,不易区别ES和其他微生物
3、TSA:多种产生黄色素沉着的肠杆菌科菌株均能生长,如:pantoea spp.,E. hermanii,E. vulneris
上一篇:基因工程的常用工具-载体
下一篇:阪崎肠杆菌检测培养基的选择



